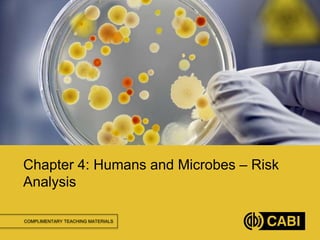
COMPLIMENTARY TEACHING MATERIALS
Chapter 4: Humans and Microbes – Risk
Analysis
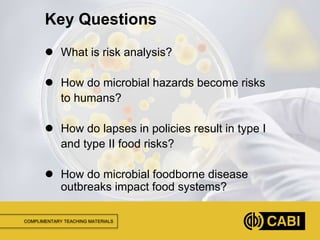
COMPLIMENTARY TEACHING MATERIALS
 What is risk analysis?
 How do microbial hazards become risks
to humans?
 How do lapses in policies result in type I
and type II food risks?
 How do microbial foodborne disease
outbreaks impact food systems?
Key Questions
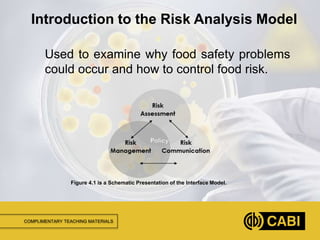
COMPLIMENTARY TEACHING MATERIALS
Used to examine why food safety problems
could occur and how to control food risk.
Introduction to the Risk Analysis Model
Figure 4.1 is a Schematic Presentation of the Interface Model.
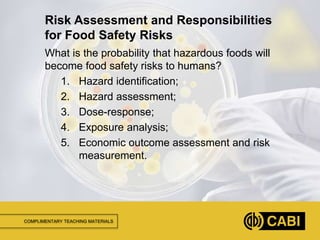
COMPLIMENTARY TEACHING MATERIALS
What is the probability that hazardous foods will
become food safety risks to humans?
1. Hazard identification;
2. Hazard assessment;
3. Dose-response;
4. Exposure analysis;
5. Economic outcome assessment and risk
measurement.
Risk Assessment and Responsibilities
for Food Safety Risks
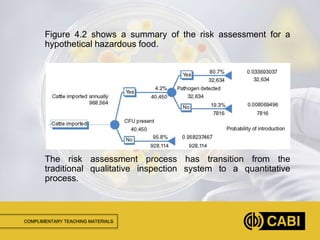
COMPLIMENTARY TEACHING MATERIALS
Figure 4.2 shows a summary of the risk assessment for a
hypothetical hazardous food.
The risk assessment process has transition from the
traditional qualitative inspection system to a quantitative
process.
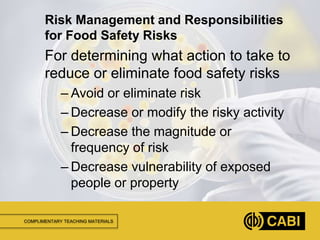
COMPLIMENTARY TEACHING MATERIALS
For determining what action to take to
reduce or eliminate food safety risks
– Avoid or eliminate risk
– Decrease or modify the risky activity
– Decrease the magnitude or
frequency of risk
– Decrease vulnerability of exposed
people or property
Risk Management and Responsibilities
for Food Safety Risks
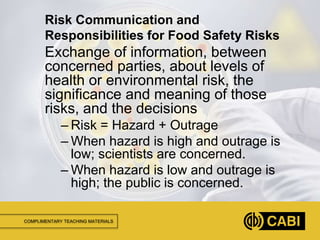
COMPLIMENTARY TEACHING MATERIALS
Exchange of information, between
concerned parties, about levels of
health or environmental risk, the
significance and meaning of those
risks, and the decisions
– Risk = Hazard + Outrage
– When hazard is high and outrage is
low; scientists are concerned.
– When hazard is low and outrage is
high; the public is concerned.
Risk Communication and
Responsibilities for Food Safety Risks
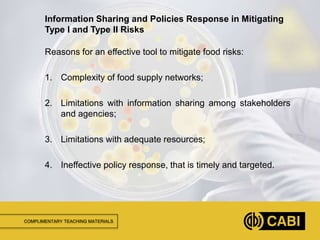
COMPLIMENTARY TEACHING MATERIALS
Reasons for an effective tool to mitigate food risks:
1. Complexity of food supply networks;
2. Limitations with information sharing among stakeholders
and agencies;
3. Limitations with adequate resources;
4. Ineffective policy response, that is timely and targeted.
Information Sharing and Policies Response in Mitigating
Type I and Type II Risks
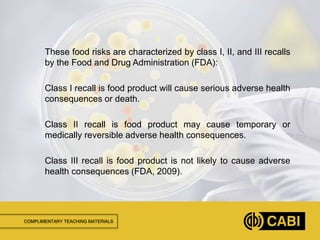
COMPLIMENTARY TEACHING MATERIALS
These food risks are characterized by class I, II, and III recalls
by the Food and Drug Administration (FDA):
Class I recall is food product will cause serious adverse health
consequences or death.
Class II recall is food product may cause temporary or
medically reversible adverse health consequences.
Class III recall is food product is not likely to cause adverse
health consequences (FDA, 2009).
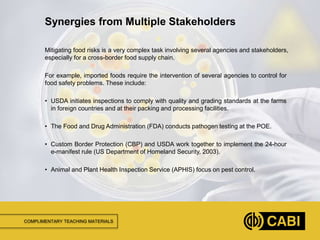
COMPLIMENTARY TEACHING MATERIALS
Mitigating food risks is a very complex task involving several agencies and stakeholders,
especially for a cross-border food supply chain.
For example, imported foods require the intervention of several agencies to control for
food safety problems. These include:
• USDA initiates inspections to comply with quality and grading standards at the farms
in foreign countries and at their packing and processing facilities.
• The Food and Drug Administration (FDA) conducts pathogen testing at the POE.
• Custom Border Protection (CBP) and USDA work together to implement the 24-hour
e-manifest rule (US Department of Homeland Security, 2003).
• Animal and Plant Health Inspection Service (APHIS) focus on pest control.
Synergies from Multiple Stakeholders
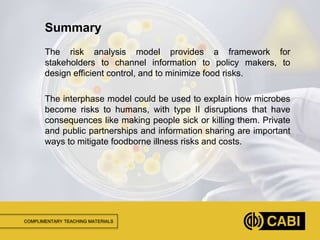
COMPLIMENTARY TEACHING MATERIALS
The risk analysis model provides a framework for
stakeholders to channel information to policy makers, to
design efficient control, and to minimize food risks.
The interphase model could be used to explain how microbes
become risks to humans, with type II disruptions that have
consequences like making people sick or killing them. Private
and public partnerships and information sharing are important
ways to mitigate foodborne illness risks and costs.
Summary

This document discusses risk analysis in food safety. It defines risk analysis as examining why food safety problems occur and how to control risks. Risk analysis includes hazard identification, assessment, exposure analysis and economic assessment. It also examines risk management which determines actions to reduce risks, and risk communication which shares information between parties. Outbreaks can impact food systems through recalls. The document proposes a framework to identify stakeholder roles and synergies, establish threat detection procedures, incentivize risk mitigation plans, and develop feedback systems to continuously improve food risk control.